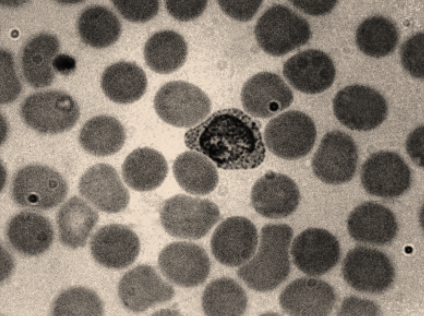
seo images

Which of the following is the adult stage of Plasmodium?
A. Trophozoite
B. Cryptozoite
C. Phanerozoite
D. None of the above
Answer
588.6k+ views
Hint: The Plasmodium has a unique and complicated life cycle involving two hosts. During feeding on the blood of humans, a malaria-infected female Anopheles mosquito inoculates sporozoites into the human host.
Sporozoites infect liver cells and mature into schizonts, which rupture and release merozoites.
Complete answer: When an Anopheles mosquito bites a healthy individual Plasmodium is introduced into the human blood in the form of the infective stage known as the sporozoite.
The injected sporozoites invade the hepatocyte cells i.e. the liver cells in the liver and then a sporozoite actively feeds on its cytoplasm and grows into an outsized (about 45 in diameter) and spherical size called as Cryptozoic.
After invading an erythrocyte, it becomes a rounded, disc-like advanced structure called trophozoites.
It is this adult stage of the parasite which is responsible for the production of the gametocytes.

So, the proper answer is option A. Trophozoite.
Note: The trophozoite state is often confused with cysts; the difference being that cysts are thick-walled rigid structures while trophozoites are often thin and delicate. They are usually smaller, measuring about an average of twenty percent of the diameter of the red blood corpuscle.
Sporozoites infect liver cells and mature into schizonts, which rupture and release merozoites.
Complete answer: When an Anopheles mosquito bites a healthy individual Plasmodium is introduced into the human blood in the form of the infective stage known as the sporozoite.
The injected sporozoites invade the hepatocyte cells i.e. the liver cells in the liver and then a sporozoite actively feeds on its cytoplasm and grows into an outsized (about 45 in diameter) and spherical size called as Cryptozoic.
After invading an erythrocyte, it becomes a rounded, disc-like advanced structure called trophozoites.
It is this adult stage of the parasite which is responsible for the production of the gametocytes.
So, the proper answer is option A. Trophozoite.
Note: The trophozoite state is often confused with cysts; the difference being that cysts are thick-walled rigid structures while trophozoites are often thin and delicate. They are usually smaller, measuring about an average of twenty percent of the diameter of the red blood corpuscle.
Recently Updated Pages
Master Class 12 Economics: Engaging Questions & Answers for Success

Master Class 12 Physics: Engaging Questions & Answers for Success

Master Class 12 English: Engaging Questions & Answers for Success

Master Class 12 Social Science: Engaging Questions & Answers for Success

Master Class 12 Maths: Engaging Questions & Answers for Success

Master Class 12 Business Studies: Engaging Questions & Answers for Success

Trending doubts
Which are the Top 10 Largest Countries of the World?

What are the major means of transport Explain each class 12 social science CBSE

Draw a labelled sketch of the human eye class 12 physics CBSE

What is a transformer Explain the principle construction class 12 physics CBSE

Why cannot DNA pass through cell membranes class 12 biology CBSE

Differentiate between insitu conservation and exsitu class 12 biology CBSE




